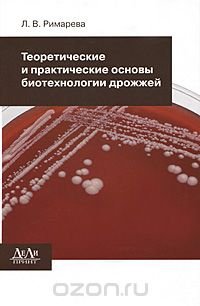

Теоретические и практические основы биотехнологии дрожжей Л. В. Римарева (книга)
Подробная информация о книге «Теоретические и практические основы биотехнологии дрожжей Л. В. Римарева». Сайт не предоставляет возможности читать онлайн или скачать бесплатно книгу «Теоретические и практические основы биотехнологии дрожжей Л. В. Римарева».
Поделиться
Рейтинг книги enc.su: 0,0
О книге
В настоящее время открываются широкие перспективы эффективного использования дрожжевых культур в различных биотехнологических процессах при производстве спирта, пива, вина, кваса, хлеба, пищевого белка, биологически активных пищевых добавок. В учебнике представлены теоретические и практические основы биотехнологии спиртовых дрожжей, даются основные представления о современных методах получения активных рас дрожжей, обладающих новыми морфолого-физиологическими и культуральными свойствами. В книге обобщены достижения современной науки в области биологии, ферментологии и микробиологии дрожжевой клетки. Подробно освещены все этапы промышленного производства и применения дрожжей в спиртовой отрасли, а также ферментных препаратов для биокатализа полимеров зернового сырья в процессе приготовления зернового сусла для генерации дрожжей и спиртового брожения. Особое внимание уделено вопросам совершенствования биотехнологических процессов спиртового производства, качеству зернового сырья и... Это и многое другое вы найдете в книге Теоретические и практические основы биотехнологии дрожжей (Л. В. Римарева)
| Полное название книги | Л. В. Римарева Теоретические и практические основы биотехнологии дрожжей |
| Тип | Книга |
| Автор | Л. В. Римарева |
| Категории | Для техникумов и вузов, Образование и наука, Книги |
| ISBN | 9785943432149 |
| Возрастное ограничение | 18 |
| Издательство | ДеЛи принт |
| Год | 2010 |
| Название транслитом | teoreticheskie-i-prakticheskie-osnovy-biotehnologii-drozhzhey-l-v-rimareva |
| Просмотров | 3 |
| Рейтинг enc.su | 0,0 |
Напишите вашу рецензию на книгу:
Л. В. Римарева «Теоретические и практические основы биотехнологии дрожжей»
Рецензии пользователей
Пока еще никто не написал рецензию на эту книгу.
